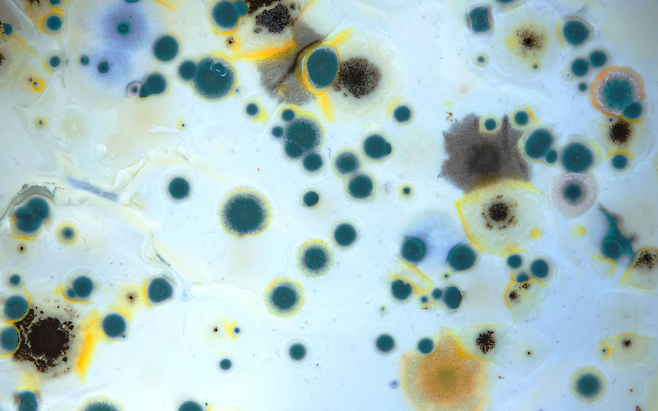

욕실은 가장 자주 청소해도 세균이 끊이지 않는 공간입니다
그런데 평소 습관처럼 욕실에 두는 한 가지 물건이 곰팡이와 세균을 급속도로 번식시킨다는 사실, 알고 계셨나요?
위생을 위해 사용하는 그것이 오히려 건강을 위협하는 원인이 될 수 있습니다. 전문가들은 욕실 안 이 물건의 방치를 특히 경고합니다.
수건을 욕실에 걸어두면 세균 번식 속도가 급증합니다

목욕 후 젖은 수건을 욕실에 그대로 걸어두는 습관은 곰팡이와 세균 증식을 부르는 대표적인 요인입니다. 욕실은 환기가 어려운 구조이며, 늘 높은 습도와 온도가 유지되는 환경이기 때문에 젖은 수건은 세균에게 이상적인 번식 장소가 됩니다.
실제로 수건을 3일 연속 욕실에 두었을 경우, 표면에서 검출되는 세균 수가 100만 마리를 넘는다는 조사도 있습니다. 겉보기엔 말라 보이지만, 직물 사이사이에 남은 습기는 완전히 마르지 않고 박테리아를 번식시키기 충분합니다.
수건에서 곰팡이 냄새가 난다면 이미 위험 신호입니다
가끔 수건에서 쿰쿰하거나 쉰 냄새가 나는 경우가 있습니다. 이는 세균이나 곰팡이균이 이미 뿌리를 내렸다는 뜻이며, 피부에 직접 닿는 수건의 특성상 접촉성 피부염, 여드름, 심할 경우 곰팡이 감염까지 유발할 수 있습니다.
면역력이 약한 어린이나 노인에게는 특히 더 치명적일 수 있습니다. 따라서 사용 후 수건은 반드시 햇볕이 잘 드는 곳이나 건조기에서 완전히 말린 후 보관하는 것이 바람직합니다.
젖은 수건은 위생용품이 아닌 세균 덩어리로 변합니다

깨끗하게 씻은 몸을 세균 번식이 가득한 수건으로 닦는다면, 청결은커녕 세균을 다시 몸에 입히는 셈입니다. 욕실 안에서는 단 한 번 사용한 수건이라도 바로 바깥으로 꺼내 말리는 것이 기본입니다.
여러 번 사용하거나 말리지 않고 재사용하는 습관은 오히려 건강을 해치는 원인이 될 수 있습니다. 특히 가족이 공동 사용하는 경우엔 세균 전파 위험도 높아집니다.

욕실은 위생의 시작점인 동시에, 관리가 부족하면 곰팡이와 세균의 온상이 되기 쉬운 공간입니다. 수건 하나만 욕실에서 꺼내는 습관으로 가족 건강을 지킬 수 있습니다.
지금 욕실에 걸려 있는 수건이 있다면, 당장 확인해보시기 바랍니다. 작은 실천 하나가 큰 건강 차이를 만듭니다.
Copyright © 뇌생각